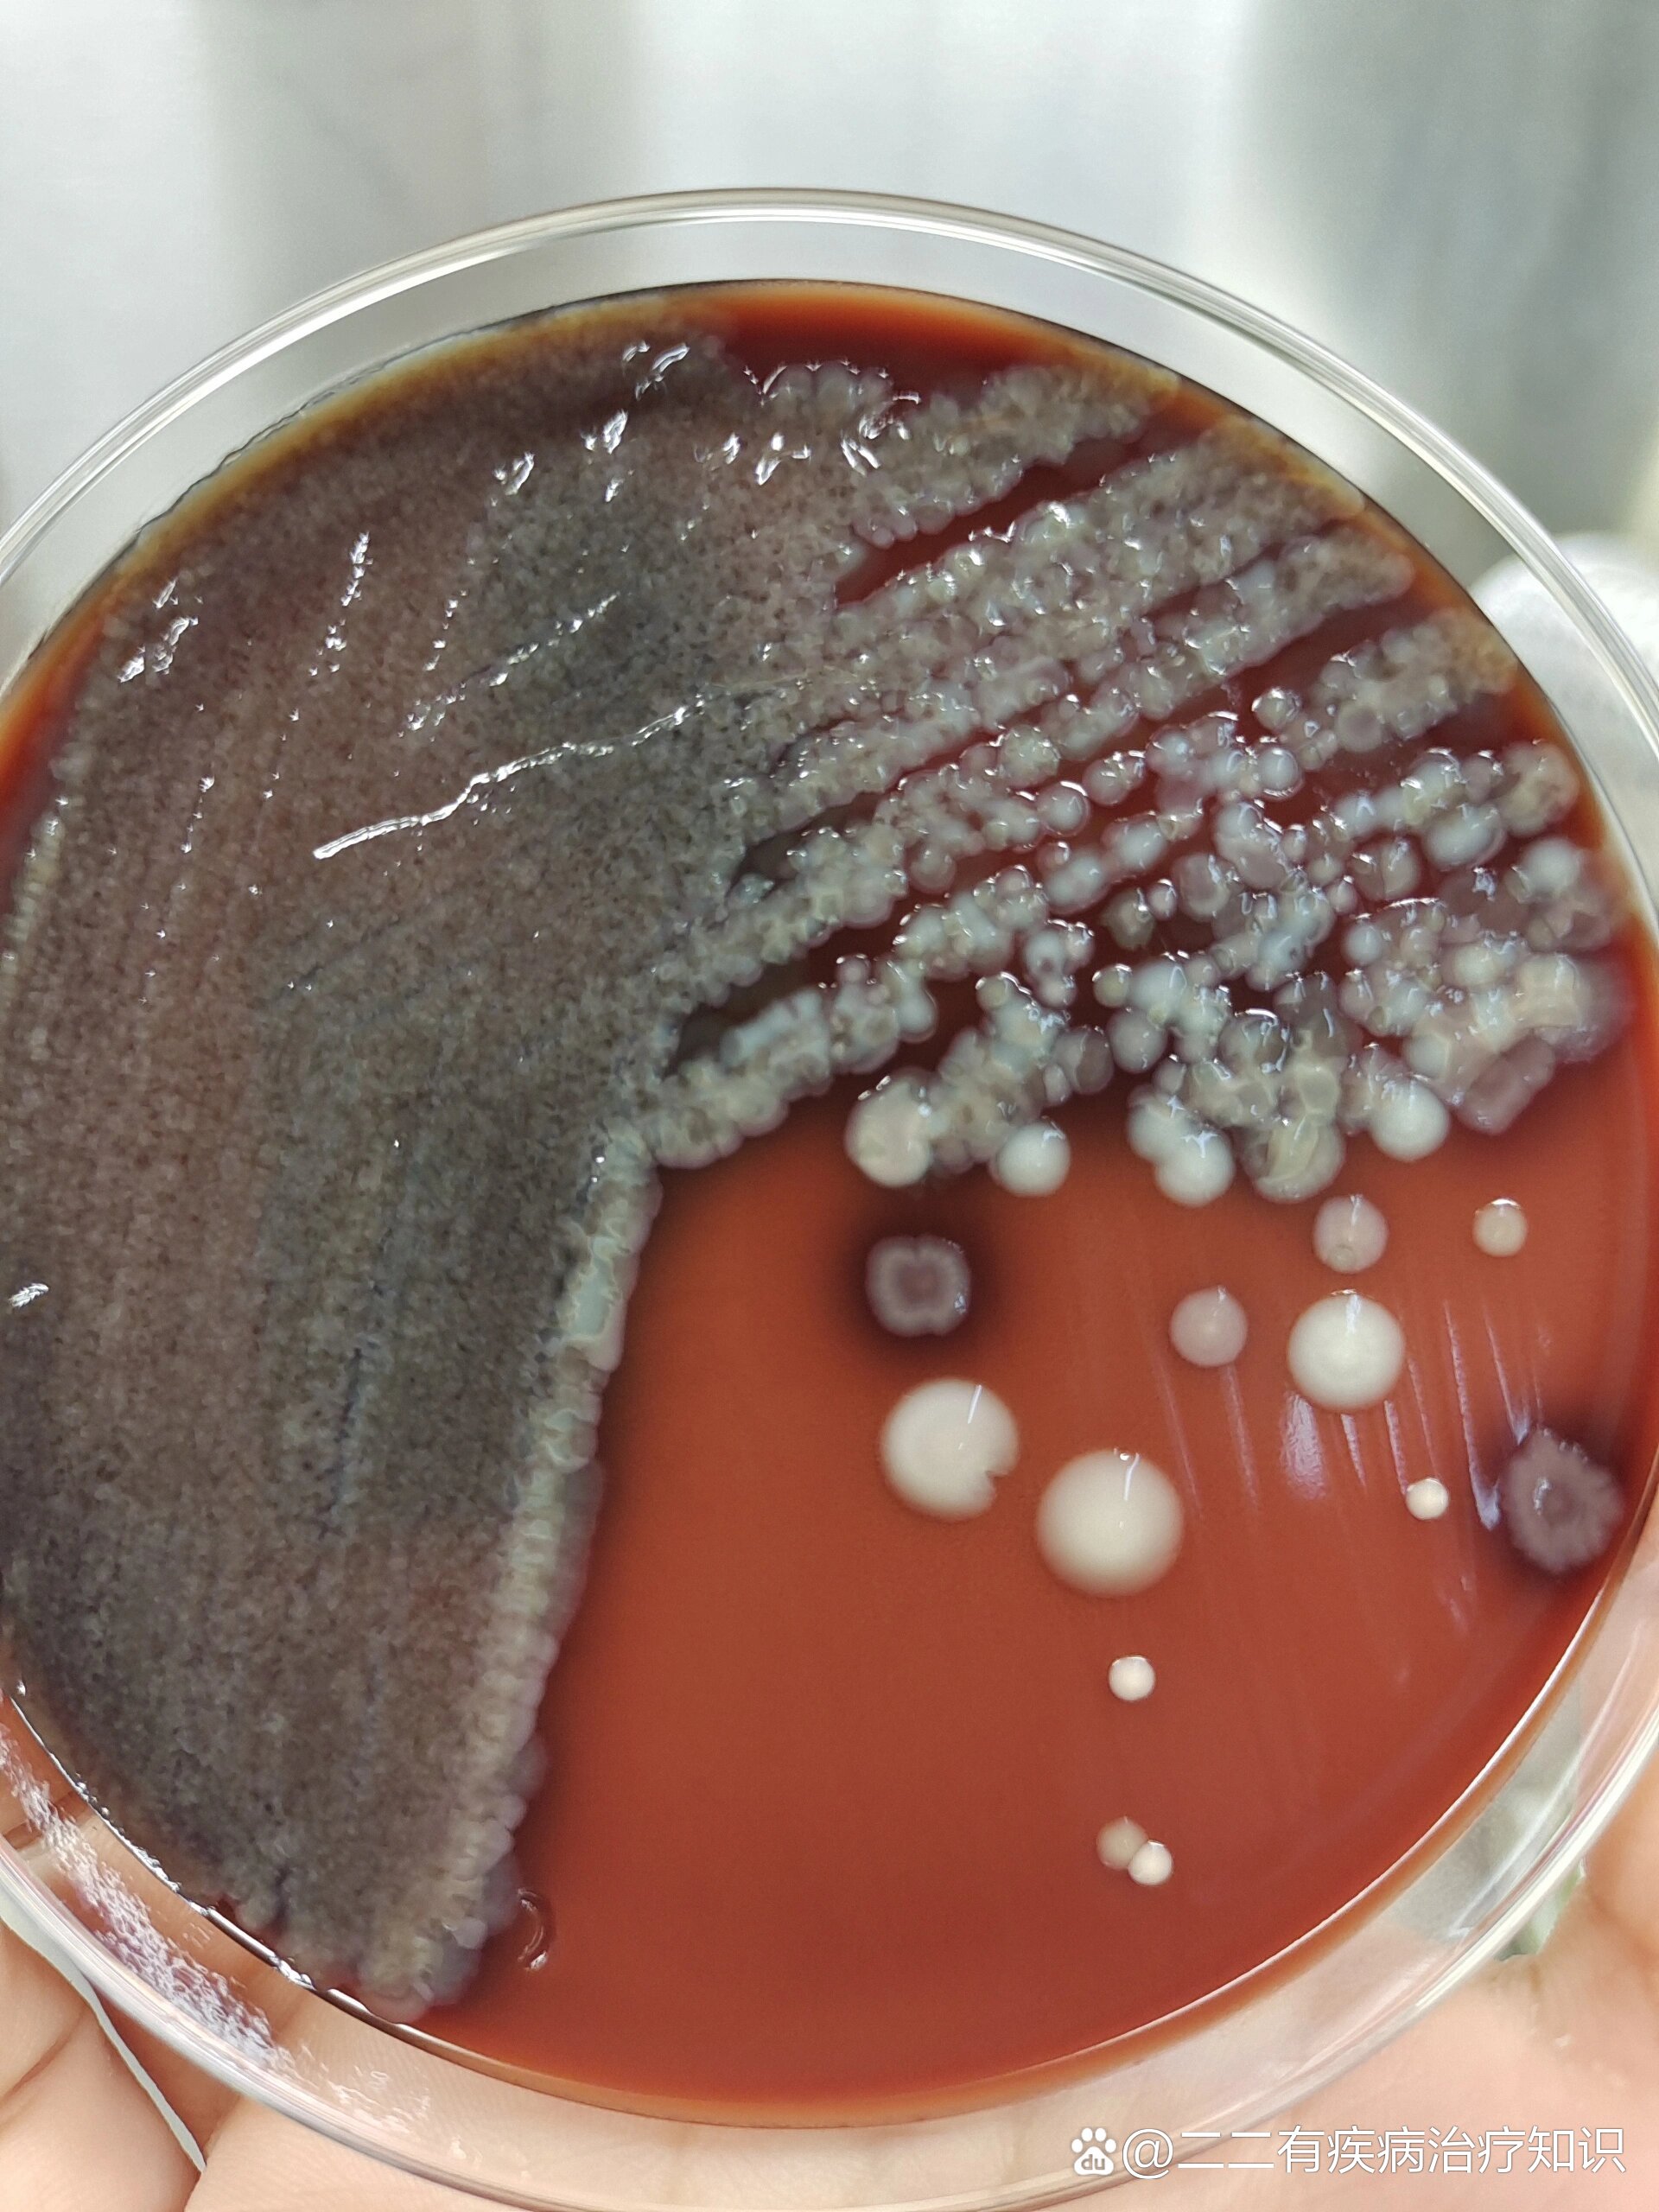
分享一例痰涂片,镜下可见大量革兰阴性杆菌

痰涂片图片

痰标本涂片合格的不好找,吞噬也不容易找到,这几张涂片值得分享和收藏
图片尺寸2049x1537痰涂片
图片尺寸1080x810痰涂片中结核分枝杆菌阳性
图片尺寸1200x900痰涂片中结核分枝杆菌阳性
图片尺寸900x1200结核分支杆菌痰涂片
图片尺寸1080x1439
痰涂片1
图片尺寸338x270痰涂片中结核分枝杆菌阳性
图片尺寸900x1200
痰涂片检查抗酸杆菌的方法有哪些?具体如何操作?
图片尺寸969x564
痰涂片,革兰氏染色,可见菌丝
图片尺寸1280x960
痰涂片?
图片尺寸980x736
痰涂片?
图片尺寸980x736痰涂片
图片尺寸1080x810
痰涂片革兰染色:革兰阳性,丝状及杆状,可见90度分枝.
图片尺寸2137x1200
市疾控中心对结核病实验室痰涂片工作进行质量核查
图片尺寸664x800
分享一例痰涂片,镜下可见大量革兰阴性杆菌
图片尺寸1920x2560
痰涂片:可见曲霉菌丝
图片尺寸1280x960痰涂片中的"学问"
图片尺寸494x371
请教,痰涂片!
图片尺寸1040x584
肺结核痰涂片视频_肺结核痰涂片图片
图片尺寸600x36364岁,直肠癌术后,痰涂片
图片尺寸744x554